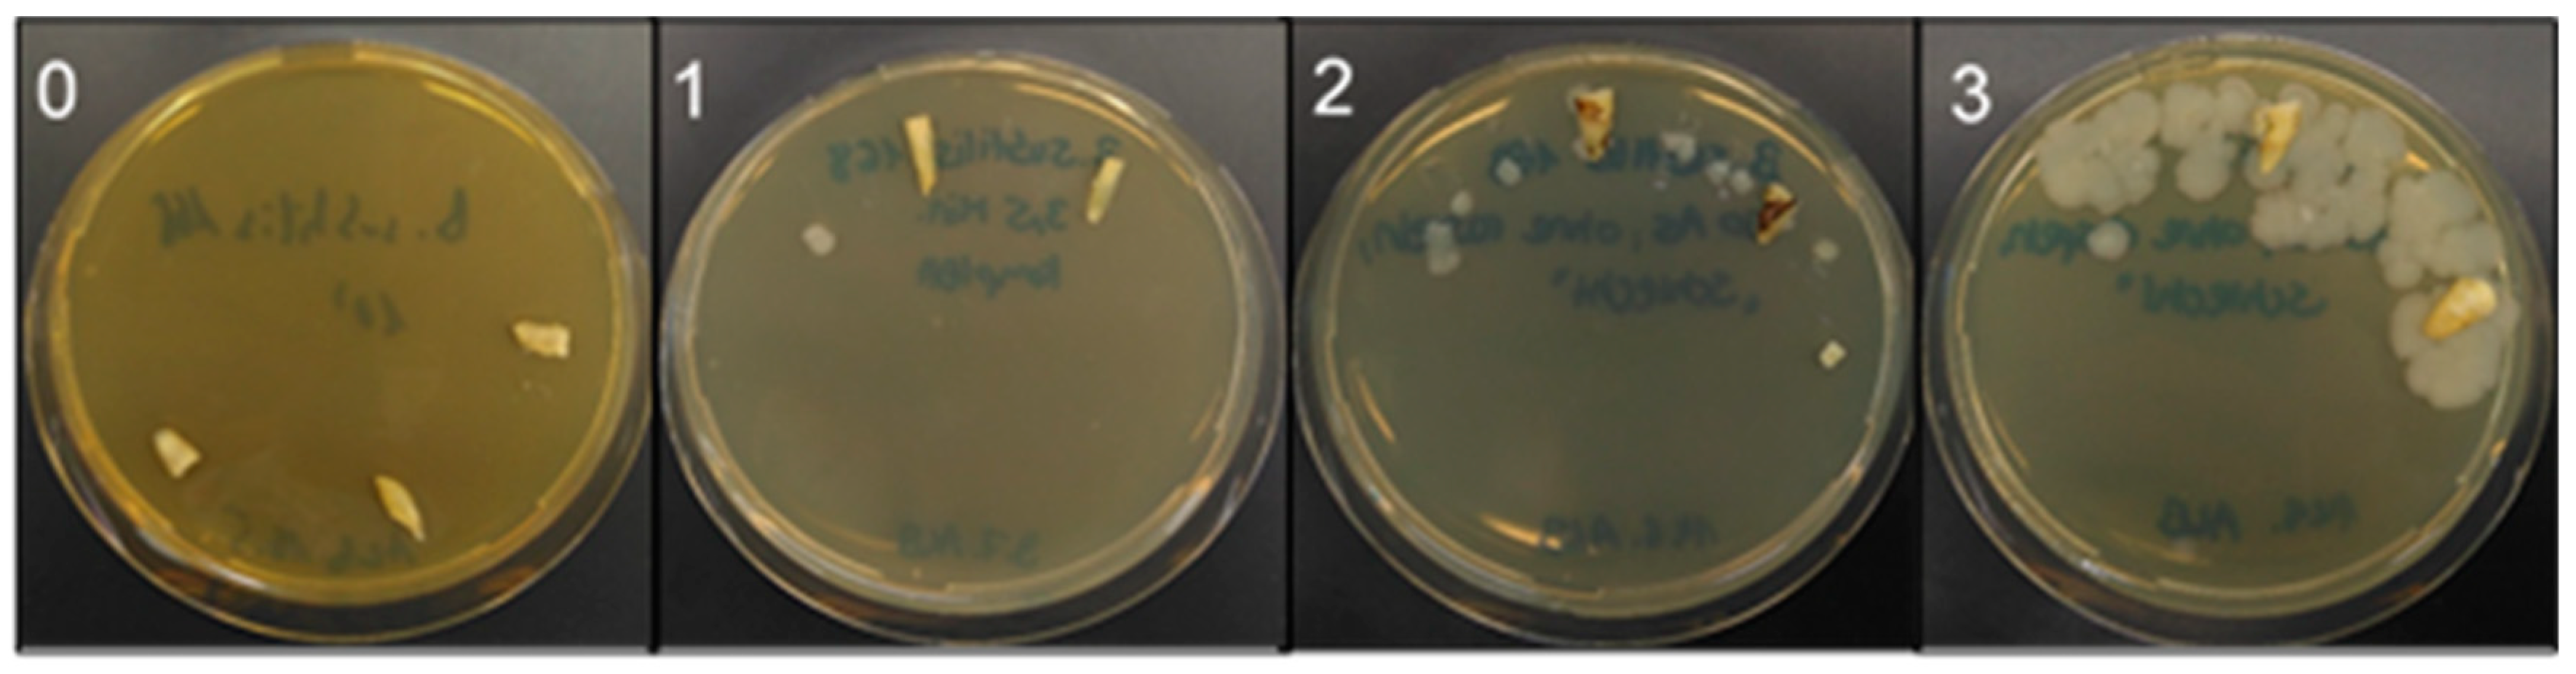
Jcm 08 02037 g006 Jcm 08 02037 g006

Electrochemical Disinfection of Experimentally Infected Teeth by Boron-Doped Diamond Electrode Treatment
Abstract
1. Introduction
2. Materials and Methods
2.1. Preparation and Infection of Extracted Teeth
2.2. BDD Electrode Treatment Systems
2.3. Analysis of Bacterial Growth
3. Results
3.1. Removal of Biofilm from Root Canals Using a Two Wire BDD Electrode (Prototype 1)
3.2. Influence of Depth of Electrode Insertion on Disinfection Success
3.3. Application of Prototype 2 BDD Electrode Suitable for Clinical Application
4. Discussion
5. Patents
Author Contributions
Funding
Acknowledgments
Conflicts of Interest
References
- Mohammadi, Z.; Palazzi, F.; Giardino, L.; Shalavi, S. Microbial biofilms in endodontic infections: An update review. Biomed. J. 2013, 36, 59–70. [Google Scholar] [CrossRef]
- Li, G.H.; Niu, L.N.; Zhang, W.; Olsen, M.; De-Deus, G.; Eid, A.A.; Chen, J.H.; Pashley, D.H.; Tay, F.R. Ability of new obturation materials to improve the seal of the root canal system: A review. Acta Biomater. 2014, 10, 1050–1063. [Google Scholar] [CrossRef]
- Bergenholtz, G.; Spångberg, L. Controversies in endodontics. Crit. Rev. Oral Biol. Med. 2004, 15, 99–114. [Google Scholar] [CrossRef]
- Gu, L.S.; Kim, J.R.; Ling, J.; Choi, K.K.; Pashley, D.H.; Tay, F.R. Review of contemporary irrigant agitation techniques and devices. J. Endod. 2009, 35, 791–804. [Google Scholar] [CrossRef] [PubMed]
- Sabeti, M.A.; Nekofar, M.; Motahhary, P.; Ghandi, M.; Simon, J.H. Healing of apical periodontitis after endodontic treatment with and without obturation in dogs. J. Endod. 2006, 32, 628–633. [Google Scholar] [CrossRef] [PubMed]
- Signoretti, F.G.; Endo, M.S.; Gomes, B.P.; Montagner, F.; Tosello, F.B.; Jacinto, R.C. Persistent extraradicular infection in root-filled asymptomatic human tooth: Scanning electron microscopic analysis and microbial investigation after apical microsurgery. J. Endod. 2011, 37, 1696–1700. [Google Scholar] [CrossRef] [PubMed]
- Tronstad, L. Recent development in endodontic research. Scand. J. Dent. Res. 1992, 100, 52–59. [Google Scholar] [CrossRef] [PubMed]
- Tronstad, L.; Asbjørnsen, K.; Døving, L.; Pedersen, I.; Eriksen, H.M. Influence of coronal restorations on the periapical health of endodontically treated teeth. Endod. Dent. Traumatol. 2000, 16, 218–221. [Google Scholar] [CrossRef] [PubMed]
- Pacheco-Yanes, J.; Provenzano, J.C.; Marceliano-Alves, M.F.; Gazzaneo, I.; Pérez, A.R.; Gonçalves, L.S.; Siqueira, J.F., Jr. Distribution of sodium hypochlorite throughout the mesial root canal system of mandibular molars after adjunctive irrigant activation procedures: A micro-computed tomographic study. Clin. Oral Investig. 2019. [Google Scholar] [CrossRef] [PubMed]
- Hope, C.K.; Garton, S.G.; Wang, Q.; Burnside, G.; Farrelly, P.J. A direct comparison between extracted tooth and filter-membrane biofilm models of endodontic irrigation using Enterococcus faecalis. Arch. Microbiol. 2010, 192, 775–781. [Google Scholar] [CrossRef][Green Version]
- Briseño-Marroquín, B.; Paqué, F.; Maier, K.; Willershausen, B.; Wolf, T.G. Root canal morphology and configuration of 179 maxillary first molars by means of micro-computed tomography: An Ex Vivo Study. J. Endod. 2015, 41, 2008–2013. [Google Scholar] [CrossRef]
- Silva, E.J.; Castro, R.W.; Nejaim, Y.; Silva, A.I.; Haiter-Neto, F.; Silberman, A.; Cohenca, N. Evaluation of root canal configuration of maxillary and mandibular anterior teeth using cone beam computed tomography: An in-vivo study. Quintessence Int. 2016, 47, 19–24. [Google Scholar] [PubMed]
- Huang, T.Y.; Gulabivala, K.; Ng, Y.L. A bio-molecular film ex-vivo model to evaluate the influence of canal dimensions and irrigation variables on the efficacy of irrigation. Int. Endod. J. 2008, 41, 60–71. [Google Scholar] [CrossRef] [PubMed]
- Gänsbauer, M.; Burkovski, A.; Karl, M.; Grobecker-Karl, T. Comparison of simplistic biofilm models for evaluating irrigating solutions. Quintessence Int. 2017, 48, 521–526. [Google Scholar]
- Burkovski, A.; Karl, M. Lack of evidence for the necessity of root canal obturation. Quintessence Int. 2019, 50, 2–8. [Google Scholar]
- Wang, Z.; Shen, Y.; Haapasalo, M. Effectiveness of endodontic disinfecting solutions against young and old Enterococcus faecalis biofilms in dentin canals. J. Endod. 2012, 38, 1376–1379. [Google Scholar] [CrossRef]
- Neelakantan, P.; Subbarao, C.V. An analysis of the antimicrobial activity of ten root canal sealers--a duration based in vitro evaluation. J. Clin. Pediatr. Dent. 2008, 33, 117–122. [Google Scholar] [CrossRef]
- Lin, J.; Shen, Y.; Haapasalo, M. A comparative study of biofilm removal with hand, rotary nickel-titanium, and self-adjusting file instrumentation using a novel in vitro biofilm model. J. Endod. 2013, 39, 658–663. [Google Scholar] [CrossRef]
- Martinho, F.C.; Gomes, A.P.; Fernandes, A.M.; Ferreira, N.S.; Endo, M.S.; Freitas, L.F.; Camões, I.C. Clinical comparison of the effectiveness of single-file reciprocating systems and rotary systems for removal of endotoxins and cultivable bacteria from primarily infected root canals. J. Endod. 2014, 40, 625–629. [Google Scholar] [CrossRef]
- Alves, F.R.; Andrade-Junior, C.V.; Marceliano-Alves, M.F.; Pérez, A.R.; Rôças, I.N.; Versiani, M.A.; Sousa-Neto, M.D.; Provenzano, J.C.; Siqueira, J.F., Jr. Adjunctive steps for disinfection of the mandibular molar root canal system: A correlative bacteriologic, micro-computed tomography, and cryopulverization approach. J. Endod. 2016, 42, 1667–1672. [Google Scholar] [CrossRef]
- Sasanakul, P.; Ampornaramveth, R.S.; Chivatxaranukul, P. Influence of adjuncts to irrigation in the disinfection of large root canals. J. Endod. 2019, 45, 332–337. [Google Scholar] [CrossRef] [PubMed]
- Beus, C.; Safavi, K.; Stratton, J.; Kaufman, B. Comparison of the effect of two endodontic irrigation protocols on the elimination of bacteria from root canal system: A prospective, randomized clinical trial. J. Endod. 2012, 38, 1479–1483. [Google Scholar] [CrossRef] [PubMed]
- Layton, G.; Wu, W.I.; Selvaganapathy, P.R.; Friedman, S.; Kishen, A. Fluid dynamics and biofilm removal generated by syringe-delivered and 2 ultrasonic-assisted irrigation methods: A novel experimental approach. J. Endod. 2015, 41, 884–889. [Google Scholar] [CrossRef] [PubMed]
- Xhevdet, A.; Stubljar, D.; Kriznar, I.; Jukic, T.; Skvarc, M.; Veranic, P.; Ihan, A. The disinfecting efficacy of root canals with laser photodynamic therapy. J. Lasers Med. Sci. 2014, 5, 19–26. [Google Scholar] [PubMed]
- Gokturk, H.; Ozkocak, I.; Buyukgebiz, F.; Demir, O. Effectiveness of various irrigation protocols for the removal of calcium hydroxide from artificial standardized grooves. J. Appl. Oral Sci. 2017, 25, 290–298. [Google Scholar] [CrossRef] [PubMed][Green Version]
- Huth, K.C.; Quirling, M.; Maier, S.; Kamereck, K.; Alkhayer, M.; Paschos, E.; Welsch, U.; Miethke, T.; Brand, K.; Hickel, R. Effectiveness of ozone against endodontopathogenic microorganisms in a root canal biofilm model. Int. Endod. J. 2009, 42, 3–13. [Google Scholar] [CrossRef]
- Azim, A.A.; Aksel, H.; Zhuang, T.; Mashtare, T.; Babu, J.P.; Huang, G.T. Efficacy of 4 irrigation protocols in killing bacteria colonized in dentinal tubules examined by a novel confocal laser scanning microscope analysis. J. Endod. 2016, 42, 928–934. [Google Scholar] [CrossRef]
- Schorr, B.; Ghanem, H.; Rosiwal, S.; Geißdörfer, W.; Burkovski, A. Elimination of bacterial contaminations by treatment of water with boron-doped diamond electrodes. World J. Microbiol. Biotechnol. 2019, 35, 48. [Google Scholar] [CrossRef]
- Karsa, D.R. Biocides. In Handbook for Cleaning/Decontamination of Surfaces; Johansson, I., Somasundaran, P., Eds.; Elsevier, B.V.: Amsterdam, The Netherlands, 2007; pp. 593–623. ISBN 978-0-444-51664-0. [Google Scholar]
- Estrela, C.; Sydney, G.B.; Figueiredo, J.A.; Estrela, C.R. A model system to study antimicrobial strategies in endodontic biofilms. J. Appl. Oral Sci. 2009, 17, 87–91. [Google Scholar] [CrossRef]
- Diesendorf, N.; Köhler, S.; Geißdörfer, W.; Grobecker-Karl, T.; Karl, M.; Burkovski, A. Characterisation of Roseomonas mucosa isolated from the root canal of an infected tooth. BMC Res. Notes 2017, 10, 212. [Google Scholar] [CrossRef]

© 2019 by the authors. Licensee MDPI, Basel, Switzerland. This article is an open access article distributed under the terms and conditions of the Creative Commons Attribution (CC BY) license (http://creativecommons.org/licenses/by/4.0/).
Share and Cite
Böhm, A.-L.; Koch, M.; Rosiwal, S.; Burkovski, A.; Karl, M.; Grobecker-Karl, T. Electrochemical Disinfection of Experimentally Infected Teeth by Boron-Doped Diamond Electrode Treatment. J. Clin. Med. 2019, 8, 2037. https://doi.org/10.3390/jcm8122037
Böhm A-L, Koch M, Rosiwal S, Burkovski A, Karl M, Grobecker-Karl T. Electrochemical Disinfection of Experimentally Infected Teeth by Boron-Doped Diamond Electrode Treatment. Journal of Clinical Medicine. 2019; 8(12):2037. https://doi.org/10.3390/jcm8122037
Chicago/Turabian StyleBöhm, Anna-Lena, Maximilian Koch, Stefan Rosiwal, Andreas Burkovski, Matthias Karl, and Tanja Grobecker-Karl. 2019. "Electrochemical Disinfection of Experimentally Infected Teeth by Boron-Doped Diamond Electrode Treatment" Journal of Clinical Medicine 8, no. 12: 2037. https://doi.org/10.3390/jcm8122037
APA StyleBöhm, A.-L., Koch, M., Rosiwal, S., Burkovski, A., Karl, M., & Grobecker-Karl, T. (2019). Electrochemical Disinfection of Experimentally Infected Teeth by Boron-Doped Diamond Electrode Treatment. Journal of Clinical Medicine, 8(12), 2037. https://doi.org/10.3390/jcm8122037

